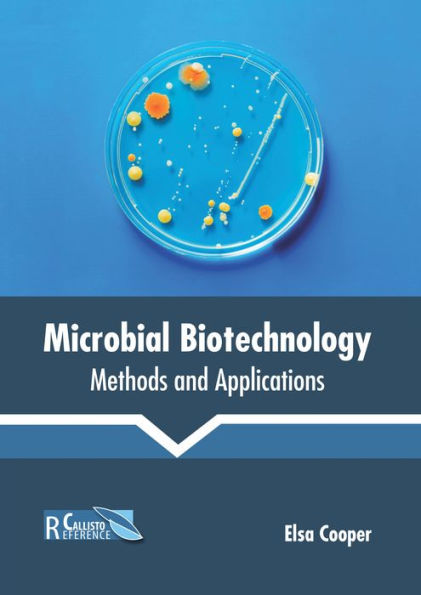
Microbial Biotechnology: Methods and Applications

Home
Microbial Bioremediation: Processes, Techniques and Applications
Barnes and Noble
Loading Inventory...
Microbial Bioremediation: Processes, Techniques and Applications in Chattanooga, TN
Current price: $146.99

Barnes and Noble
Microbial Bioremediation: Processes, Techniques and Applications in Chattanooga, TN
Current price: $146.99
Loading Inventory...
Size: OS
Microbial bioremediation is a process that uses microbes for the decay of contaminated media like soil, water, etc. It is a sustainable and cost-effective process. Bioremediation involves stimulating the growth of microorganisms with the addition of microbial cultures to the polluted media which then break down organic substances through oxidation-reduction reactions. Some popularly used technologies in this field include phytoremediation, mycoremediation, bioventing, bioaugmentation, etc. This book covers advanced concepts and theories related to bioremediation. It also elucidates new techniques and their applications in a multidisciplinary manner. The book is appropriate for students seeking detailed information in this area as well as for experts. It will help the readers in keeping pace with the rapid changes in this field.
Microbial bioremediation is a process that uses microbes for the decay of contaminated media like soil, water, etc. It is a sustainable and cost-effective process. Bioremediation involves stimulating the growth of microorganisms with the addition of microbial cultures to the polluted media which then break down organic substances through oxidation-reduction reactions. Some popularly used technologies in this field include phytoremediation, mycoremediation, bioventing, bioaugmentation, etc. This book covers advanced concepts and theories related to bioremediation. It also elucidates new techniques and their applications in a multidisciplinary manner. The book is appropriate for students seeking detailed information in this area as well as for experts. It will help the readers in keeping pace with the rapid changes in this field.